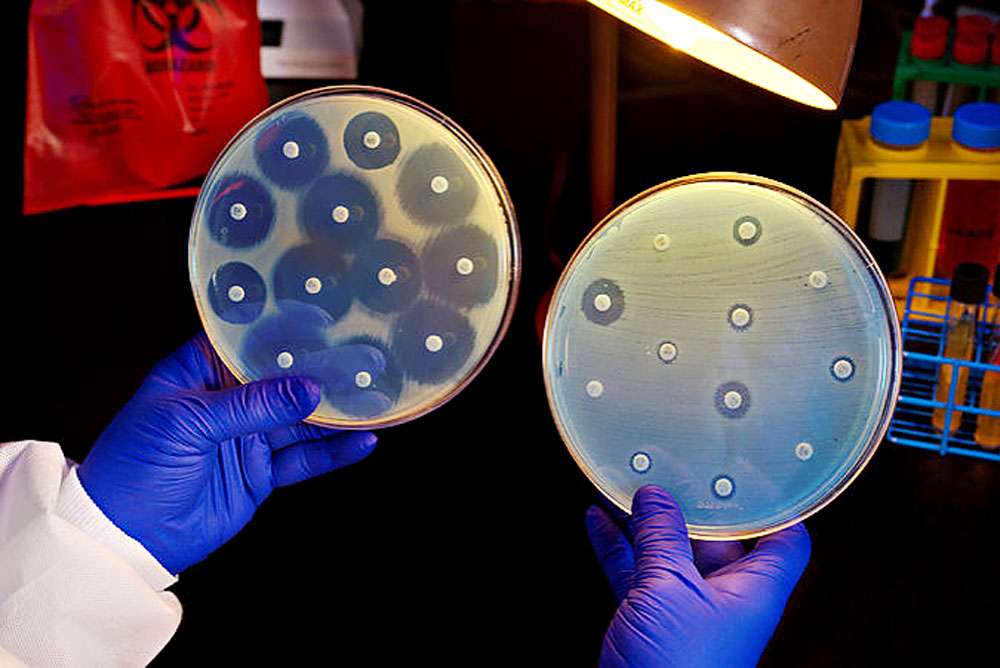

COVID-19: A Global Health Crisis The COVID-19 outbreak, first identified in Wuhan, China, emerged as a cluster of patients with fever and respiratory symptoms on December 31, 2019. The World Health Organization (WHO) declared it a Public Health Emergency of International Concern (PHEIC) on January 31, 2020, and later labeled it a pandemic on March…
The new case of Ebola Virus Disease in Beni is linked to the 2018-2020 Nord Kivu/Ituri EVD outbreak and does not represent a new spillover event. On October 08, 2021, a case of Ebola virus disease (EVD) was confirmed in a 29-month-old male child, living in Butsili health area in the Beni health zone,…
As President Trump recovers from Covid-19, he has been singing the praises of an experimental monoclonal antibody cocktail made by Regeneron, which he credits for his fast recovery. He’s not alone in his optimism. Some infectious disease experts anticipate that monoclonal antibody treatments will become a significant tool in controlling the pandemic, potentially as valuable…
Three more cases have been reported in a new Ebola outbreak in the Democratic Republic of the Congo’s (DRC’s) Equateur, and health officials have fleshed out more details about the cluster of cases. Yesterday the World Health Organization (WHO) announced that the DRC had notified it of an outbreak in the northwestern part of the country…
ADDIS ABABA, ETHIOPIA, 7 MARCH 2020. The Africa Centres for Disease Control and Prevention (Africa CDC) confirms that the 2019 novel coronavirus disease (COVID-19) has now been reported in several African countries, with cases in Algeria, Cameroon, Egypt, Morocco, Nigeria, Senegal, South Africa, Togo, and Tunisia. It’s important to emphasize that we anticipated that this…